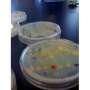

Dear Reader ,
Here is your customized Science X Newsletter for June 7, 2016:
Spotlight Stories Headlines
Astronomy & Space news
 | Astronomers discover a giant planet spinning up its star(Phys.org)—A giant "hot Jupiter" exoplanet has recently been detected by an international team of astronomers led by Kaloyan Penev of Princeton University. The newly found alien world, designated HATS-18b, is an interesting case of a planet tidally spinning up its parent star. Moreover, this planetary system could be a great laboratory for researchers when it comes to testing theories of planet–star interactions. The new findings were presented in a paper published online on June 2 on arXiv.org. |
 | Universe's first life might have been born on carbon planetsOur Earth consists of silicate rocks and an iron core with a thin veneer of water and life. But the first potentially habitable worlds to form might have been very different. New research suggests that planet formation in the early universe might have created carbon planets consisting of graphite, carbides, and diamond. Astronomers might find these diamond worlds by searching a rare class of stars. |
 | Asteroseismologists listen to the relics of the Milky WayAstrophysicists from the University of Birmingham have captured the sounds of some of the oldest stars in our galaxy, the Milky Way, according to research published today in the Royal Astronomical Society journal Monthly Notices. |
 | Researchers use network theory to solve the mystery of stellar initial mass functionFor the first time, scientists have used methods of network science to solve a fundamental astrophysical problem—explaining the so-called "stellar initial mass function," a distribution of stars by mass in galaxies and star clusters. The study has been published in the recent issue of The Astrophysical Journal. |
 | Image: A mysterious ring of celestial microwavesFifty years ago, astronomers discovered a mystery. They called it Loop I. Today, we still have not fully resolved the mystery of how this giant celestial structure formed but we do now have the best image of it, thanks to ESA's Planck satellite. |
 | Computer simulations shed light on the Milky Way's missing red giantsNew computer simulations from the Georgia Institute of Technology provide a conclusive test for a hypothesis of why the center of the Milky Way appears to be filled with young stars but has very few old ones. According to the theory, the remnants of older, red giant stars are still there—they just aren't bright enough to be detected with telescopes. |
 | Image: Space station view of rare noctilucent cloudsExpedition 47 Flight Engineer Tim Peake of the European Space Agency photographed rare, high-altitude noctilucent or "night shining" clouds from the International Space Station on May 29, 2016. |
 | From dark gravity to phantom energy: what's driving the expansion of the universe?There is something strange happening in the local universe, with galaxies moving away from each other faster than expected. |
 | Collaboration uncovers the origin of extraordinary supernovaeAstronomers using the OISTER telescope consortium in Japan have uncovered new information about the origin of 'extraordinary supernovae' explosions, which are brighter than normal ones. This new information will help improve measurements of the Universe's expansion, and of the Dark Energy which controls the final fate of the cosmos. |
 | Space feat opens 'new window' onto UniverseA ground-breaking physics mission has opened up space as the next frontier for exploring a ubiquitous, invisible force predicted by Albert Einstein a century ago, project leaders said Tuesday. |
 | SOFIA heads to New Zealand to study Southern Hemispheric skiesThe Stratospheric Observatory for Infrared Astronomy, SOFIA, arrived in Christchurch, New Zealand, to study the Southern Hemisphere's skies June 6. |
Technology news
 | Finns to bury nuclear waste in world's costliest tombDeep underground on a lush green island, Finland is preparing to bury its highly-radioactive nuclear waste for 100,000 years—sealing it up and maybe even throwing away the key. |
 | Protective hearing tech in the Army: Not too loud and not too soft(Tech Xplore)—Soldiers' ears have had a tough challenge. Historically, soldiers have had to choose between hearing protection and force protection. In other words, maintaining situational awareness was not in line with the need to maintain hearing protection. Not good. |
 | Space engineers develop green, solar-powered air conditioningThe ingenuity of four space engineers has created a zero-emission air-conditioning system that doesn't pollute our atmosphere when we turn it on. |
 | Origami ninja star inspires new battery designA new disposable battery that folds like an origami ninja star could power biosensors and other small devices for use in challenging field conditions, says an engineer at Binghamton University, State University of New York. |
Solar-powered airplane's flight to New York City postponedThe latest leg of a solar-powered airplane's around-the-world journey has been postponed due to weather conditions. | |
Viacom owner throws up hurdle to Paramount saleIn a move that further undermines Viacom CEO Philippe Dauman, the company's controlling shareholder said Monday it amended Viacom's bylaws to require unanimous board approval for any full or partial sale of movie studio Paramount Pictures. | |
Apple hopes to spark its developers' enthusiasmNext week, one of the biggest Silicon Valley-area events of the season will occur. No, it's not the potential Game 5 of the NBA Finals, as the Golden State Warriors seek to retain their league title. Nor is it what for many parents will be the start of having their kids at home for two months of summer vacation. | |
New tool could help investors pick the clean energy project right for themIn 2013, Serbia announced its goal of having 27 percent of the country's power be generated from renewable sources by 2020. Hitting that target will require building additional clean energy facilities, but figuring out what type of project—solar, wind, hydropower or other renewable sources—to support can be a daunting task for investors. | |
 | Safety—or profit? The booming business of CCTV and safer streetsClosed circuit street cameras have been sold to the community as a way of making us safer, reducing crime and discouraging anti-social behaviour. But research into the Federal Government's $50 million Safer Streets program shows its main effect has been unchecked proliferation of highly profitable commercial arrangements between governments and private firms, amid little evidence that it improves public safety. |
 | Computing helps with the complex design of modern architectureIn 1960, when the America computer scientist Ivan Sutherland developed Sketchpad, described as the first computer graphical user interface, it changed the course of architecture. |
 | Germany demands tougher rules on emissions testingGermany on Tuesday demanded tougher rules on controlling diesel car pollution in Europe as it blamed auto manufacturers other than Volkswagen of using defeat devices to pass emissions tests. |
 | Millennials still consume news, but on their phones, survey findsAccording to the Pew Research Center, more than two thirds of U.S. adults own smart phones and more than 85 percent of millennials own the devices. As the journalism industry searches for ways to adapt to this changing technological landscape, researchers from the Reynolds Journalism Institute (RJI), housed at the University of Missouri School of Journalism, conducted a national survey of 1,000 smartphone users to better understand how they used their devices when consuming news. The survey revealed that 75 percent of adults 18-44 years of age frequently use their smartphones to consume news. |
 | Using computers to better understand artHow do humans interpret and understand art? The nature of artistic style, seemingly abstract and intuitive, is the subject of ongoing debate within art history and the philosophy of art. |
 | Flight of the RoboBeeIncreasingly, researchers are designing robots with forms and functions that defy our expectation of what a machine can be or do. |
 | You are not as anonymous as you think onlineYou may not be anonymous as you think you are online; reveals a new study published on Frontiers in ICT. Your browsing behavior can indicate your personality and provide a unique digital signature which can identify you, sometimes after just 30-minutes of browsing. |
 | UNIST introduces the world to the smart urban vehicle conceptUlsan National Institute of Science and Technology (UNIST) is ready to bring nimble, urban-friendly motoring to South Korea's crowded city centers with a fleet of its brand new ultra-compact foldable electric vehicle for urban mobility. Besides its absolutely innovative design, this electric vehicle concept will feature lightweight body and stunning performance. |
 | Towards building next-generation batteries using a pigment electrodeCalcium ion batteries (CIBs) have attracted much attention as next-generation batteries to replace lithium ion batteries (LIBs) because the theoretical capacity of CIBs is twice that of LIBs. This doubled capacity can be explained by the difference between monovalent and divalent ions. In addition, CIBs possess advantages such as a lower cost and higher safety because calcium is more abundant than lithium and because CIBs have a higher melting point than LIBs. However, there is one major obstacle to the application in CIBs. There is no suitable electrode material in which calcium ions can be inserted and extracted reversibly because of the relatively large ionic radius of calcium ions (112 pm) as compared to that of lithium ions (76 pm). |
 | Researchers find weak spots in Europe's 'Right to be Forgotten' data privacy lawUnder Europe's "Right to be Forgotten" law, citizens there can petition Internet search providers such as Google to remove search results linked to personal information that is negative or defamatory. In many cases, these links lead to information about accusations of criminal activity or financial difficulties, which may be "delisted" if the information is erroneous or no longer relevant. |
GM wants to keep steering wheels, pedals in self-driving carsGeneral Motors chief executive Mary Barra came out strongly Tuesday for regulations requiring the retention of steering wheels and foot pedals in self-driving cars. | |
 | How 4D simulation can help construction projects come in on time—and on budgetMassive public transportation infrastructure projects are notorious for exceeding both budgets and deadlines. Think Boston's Big Dig, finally completed eight years late and billions of dollars over budget. |
 | Energy crowdfunding: the new way to boost renewablesIt's a brand new sector: the first steps date back to 2012. Today energy crowdfunding is a way of financing solar panel or wind turbine projects. For some people, like Andrew Yakub, founder of a US solar manufacturing company, it will save the planet. |
 | PolyU invention makes 3D mapping more accurateThe two major traditional 3D mapping techniques are photogrammetry using satellite/aerial imagery and laser scanning. The former offers higher accuracy in the horizontal direction while the latter shows higher accuracy in vertical direction. They may produce errors at different levels and there are usually inconsistences between the mapping products derived from them. |
 | Deep learning helps to map Mars and analyze its surface chemistryResearchers at the University of Massachusetts Amherst and Mount Holyoke College are teaming up to apply recent advances in machine learning, specifically biologically inspired deep learning methods, to analyze large amounts of scientific data from Mars. |
Medicine & Health news
 | Down's syndrome 'treated' with green tea: studyA chemical in green tea has been shown to improve cognitive ability in persons with Down's syndrome, scientists and doctors said Tuesday. |
 | Swapping sick for healthy brain cells slows Huntington's diseaseResearchers have successfully reduced the symptoms and slowed the progression of Huntington's disease in mice using healthy human brain cells. The findings, which were published today in the journal Nature Communications, could ultimately point to a new method to treat the disease. |
 | Real-time view of enteric nervous system provides new way to study gastrointestinal disordersDuke researchers have developed a system that allows real-time optical and electrical observations of the gut's nervous system in a live animal. |
 | Anesthesia is safe in the young, study findsA single exposure to general anesthesia poses no cognitive risk to healthy children under age three, a critical time in brain development, according to a multicenter study led by researchers at Columbia University Medical Center and NewYork-Presbyterian/Morgan Stanley Children's Hospital. Findings from the study, the largest and most comprehensive of its kind, were published today in the Journal of the American Medical Association. |
 | Vaccine watches bacteria, strikes only when trouble stirsA new vaccine allows pneumonia-causing bacteria to colonize inside the body, springing into action only if the bacteria pose a threat. |
 | Myelination depends on mechanical as well as chemical signaling—new path to treatments for myelin diseases like MSMechanical forces play a critical role in myelination, the formation of the protective coating that neurons need to function, researchers at the University at Buffalo have discovered. |
 | Using CRISPR to grow a human pancreas in a pig(Medical Xpress)—A team of researchers at the University of California, Davis, the BBC is reporting, has begun conducting experiments designed to learn how to use the CRISPR gene editing technique to grow human organs in live pigs. Thus far, they have allowed a human pancreas to grow inside of a test pig for up to 28 days before ending the pregnancy. |
 | Larger wine glasses may lead people to drink moreSelling wine in larger wine glasses may encourage people to drink more, even when the amount of wine remains the same, suggests new research from the University of Cambridge. In a study published today in the journal BMC Public Health, researchers found that increasing the size of wine glasses led to an almost 10% increase in wine sales. |
 | Blood test to personalize depression treatment for the first timeScientists at King's College London have developed a blood test that accurately and reliably predicts whether depressed patients will respond to common antidepressants, which could herald a new era of personalised treatment for people with depression. |
Moving can be hazardous to your health and wellbeingAn extensive, long-term study of Danish children followed into adulthood shows that moving to a new home during childhood increases the likelihood of multiple adverse outcomes later in life. This unique residential mobility study of 1.4 million people tracked from their 15th birthdays until their early forties appears in the American Journal of Preventive Medicine. | |
 | Saturated fatty acids linked to breast cancer in postmenopausal womenFatty acids in the breast may be useful indicators of cancer in postmenopausal women, according to a new study published online in the journal Radiology. The results may help researchers determine the underlying mechanisms behind breast cancer development in some patients. |
 | What happens when parents comment their daughter's weight?The less you comment on your daughter's weight, the less likely she is to be dissatisfied with her weight as an adult according to a new study from the Cornell Food and Brand Lab. |
 | Mediterranean diet high in healthy fat does not lead to weight gain, according to randomized trialFocus on low-fat diets and lack of differentiation between healthy and unhealthy fat has led to 'paradoxical policies' about healthy eating |
 | Hip arthroscopy often not the best option for older patients(HealthDay)—Many patients in their 60s who have hip arthroscopy need total hip arthroplasty (THA) within two years, according to research published in the April issue of Arthroscopy: The Journal of Arthroscopic and Related Surgery. |
New synthetic drug U-47700 has states rushing to stop spreadA new synthetic drug that can be purchased online and is connected to at least 50 deaths nationwide has several states scrambling to stop its spread, with Kansas law enforcement agencies seeking an emergency ban. | |
 | Lung cancer: Mobile app could extend life expectancyA new mobile application could help doctors better provide care to patients with advanced lung cancer, perhaps even extending life expectancy, according to a study presented in the United States Monday. |
 | Rapid mood changes normal for teensDear Mayo Clinic: My 13-year-old daughter has become very moody, which I realize is normal for this age. But, I'm concerned she may be depressed. What is the difference between typical teen behavior and depression in teenagers? Are there certain things I should watch for that could be signs of depression? |
Study finds opposing trends in hospitalizations, costs for gout and rheumatoid arthritisWhile hospitalizations related to rheumatoid arthritis have dropped considerably over the past two decades, hospitalizations primarily associated with gout have increased dramatically. These results of a study described in a research letter in the June 7, 2016 issue of JAMA reflect improved management of rheumatoid arthritis patients and both an increased prevalence and persistent suboptimal care of gout. | |
Screening for syphilis recommended for persons at increased risk of infectionThe U.S. Preventive Services Task Force (USPSTF) has found convincing evidence that screening for syphilis infection in asymptomatic, nonpregnant persons at increased risk for infection provides substantial benefit. The report appears in the June 7 issue of JAMA. | |
 | Findings suggest small increase in obesity among US teens in recent yearsAmong U.S. children and adolescents 2 to 19 years of age, the prevalence of obesity in 2011- 2014 was 17 percent, and over approximately the last 25 years, the prevalence has decreased in children age 2 to 5 years, leveled off in children 6 to 11 years, and increased among adolescents 12 to 19 years of age, according to a study appearing in the June 7 issue of JAMA. |
Prevalence of obesity in the US increases among women, but not menThe prevalence of obesity in 2013- 2014 was 35 percent among men and 40 percent among women, and between 2005 and 2014, there was an increase in prevalence among women, but not men, according to a study appearing in the June 7 issue of JAMA. | |
 | Study reveals the best way to improve muscle strengthEngaging in short, explosive leg contractions is the most effective way of strengthening muscles, Loughborough research reveals. |
Decline of public substance use disorder treatment facilities has greater impact on counties with more black residentsThe overall decline of public substance use disorder treatment facilities has disproportionately impacted counties with high shares of black residents, where private facilities are less likely to be located, according to a study being released in the June issue of the journal Health Affairs. | |
 | Five things you should know about grilling burgers to avoid getting sickFor many people, the sound of burgers sizzling on the grill is enough to make their mouths water. Grilling burgers is a great opportunity to spend time with family and friends, whether it's at a summer party in the backyard or tailgating in the autumn. But grilling burgers can also lead to vomiting, diarrhea and all the other health effects associated with foodborne illness. |
Cancer patients with ACA policies swiftly reach out-of-pocket capsA hypothetical leukemia patient buying the life-extending drug therapy for his condition would reach his annual out-of-pocket maximum in a month on most of the bronze policies and half of the silver policies offered through the Affordable Care Act marketplace. | |
Poliovirus therapy shows survival benefit in early patientsAn early group of patients who received a modified form of the poliovirus to treat recurrent glioblastoma brain tumors showed survival improvement over historical controls, according to researchers at the Preston Robert Tisch Brain Tumor Center at Duke Health. | |
Immunotherapy treats aggressive form of lymphomaA drug that recruits immune cells to fight an aggressive form of lymphoma that disproportionately affects minorities in the United States appears to be more effective than chemotherapy, according to new research from Weill Cornell Medicine and NewYork-Presbyterian. | |
Early assessment, drug switch improves cancer treatmentMetastatic prostate cancer patients respond better to treatment when they switch to different drugs in the absence of an optimal initial response, according to new research from Weill Cornell Medicine and NewYork-Presbyterian. | |
 | Research shows marriage could improve heart attack survivalBeing married could improve your likelihood of surviving a heart attack and is associated with reduced length of hospital stay - according to UEA research presented at the British Cardiovascular Society (BCS) Conference in Manchester today. |
Smartphones won't make your kids dumb. We think.Like many parents, Sandy is concerned about how much time her 18-month-old spends in front of screens. Weighing up the available evidence, Olivia Solon explains that she might be worrying too much. Jessica's tiny fingers dart around the iPad, swiping through photos to get to a particularly entertaining video: a 12-second clip of her dancing clumsily to Beyoncé's Single Ladies. The 18-month-old taps "play" and emits a squeal of delight. | |
 | Word choice—hidden meanings can influence our judgmentWhy is it worse when someone causes work for us rather than produces work for us? Why does each word prompt a different interpretation of "work," with "caused" work seeming burdensome and "produced" work seeming advantageous? |
 | Using games to reduce drug errorsAn educational board game designed to help frontline healthcare professionals to understand, recognise and minimise medication errors has been developed by Focus Games Ltd in partnership with academics from the School of Health Sciences at City University London and Health Education England. |
 | Angina drug could inform a new strategy to fight cryptococcosisA drug, more commonly used in the treatment of angina, could be the focus of a new strategy in fighting the fatal fungal infection cryptococcosis. |
 | The mechanisms responsible for human egg agingYale School of Medicine researchers have identified the molecular pathways involved in the aging of human eggs. This research could eventually lead to treatments to correct age-related damage and improve fertility in women age 40 and older. |
 | How do drivers compensate for inattention?A new QUT study will look at how people juggle driving while using their mobile phone, with research suggesting drivers try to compensate for their dangerous behaviour as a way to improve safety. |
 | Outsmarting amnesia: Research points to a new way of forming memoriesThe scene plays out like a horrifying movie. A woman wakes up in a hospital bed, with no idea how she got there, or even who she is. For another patient down the hall, things are even worse—he can recall his past, but can no longer make new memories, and so exists in a perpetual state of limbo. He forgets new faces as soon as they leave from sight. He's unable to recall any recent conversations, or even his own age. |
A country's level of education correlates well with life expectancy at birthThe level of education in a given country correlates well with life expectancy at birth, according to a new study published in the International Journal of Innovation and Learning. The researchers suggest that educating the young as well as encouraging lifelong learning could both improve the figures still further. | |
Chernobyl radiation could be linked to rising number of thyroid cancers in Belgian childrenExposure to radioactive fallout from the April 1986 Chernobyl nuclear accident in Belgium may have increased the incidence of thyroid cancer in those exposed as children, according to new research published in the journal Acta Chirurgica Belgica. | |
Early detection, smaller cancer among benefits of skin cancer screening at PCP visitsSkin cancer screenings performed by primary care physicians (PCPs) during routine office visits improve the detection of potentially deadly melanomas and find them in earlier stages, according to new research from the University of Pittsburgh School of Medicine. | |
 | Triggers for migraine attacks determined for individual patientsMigraine is the third commonest disorder in the world and ranks sixth amongst more than 300 diseases when it comes to the burden it represents. "Determining the factors that trigger migraine attacks is an important, albeit difficult, step in managing migraine," explains Christian Wöber, head of the section specializing in headaches at MedUni Vienna's Department of Neurology. Reliable indications cannot be obtained merely by asking sufferers but rather they need to keep detailed records in a diary and this data must then undergo complex statistical analysis in order to be able to treat migraine on an individual basis. This is precisely what a new study has shown. |
 | New interactive app encourages users to adopt healthier lifestylesThe EU PRECIOUS project is harnessing the power of smartphones to help users better track their fitness and encourage healthier lifestyle options. |
 | Are my cosmetics a health risk? Seeking straight answers to tricky questionsLessons from the field of medicine could help provide clearer answers to questions about chemical safety, according to researchers. |
 | New study shows NHS weekend effect among heart patientsPatients suffering from the most common form of heart rhythm disorder who are admitted to NHS hospital over the weekend face a higher risk of dying over the next five years than those admitted during normal hours. The new research was led by Dr Rahul Potluri, founder of the ACALM study unit at Aston University and will be presented at the British Cardiovascular Society (BCS) Conference 6-8 June. |
 | People with significant heart disease less able to cope with mental stressMental stress could put heart disease patients at increased risk of a dangerous event, such as a heart attack, according to research carried out at King's College London and St Thomas' Hospital, and presented at the British Cardiovascular Society (BCS) Conference in Manchester today. |
 | Some Asian-Americans are predisposed to want more carbs and fast foodRice anyone? How about a bowl of ramen noodles? Researchers have found that some Asian-Americans are more likely to hunger for carbohydrates and unhealthy foods than other Asian-Americans—and the reason appears to be genetic. |
Benefits to timing chemotherapy to body's 'awake' timeNot a morning person? Neither are your kidneys. Research from the Washington State University College of Pharmacy suggests there may be benefits to timing chemotherapy in cancer patients to the time of day the body is "most awake." | |
Study: Facing suicide attempts as a teenager could predict heart disease later in lifeTeenagers, particularly boys, who try to kill themselves or are close with someone who attempted suicide could face a higher rate of risk factors for heart disease in their twenties, according to research published by the American Psychological Association. | |
Anorexia nervosa: Pleasure at getting thin more than fear of getting fatA study from Inserm, Paris Descartes University and Sainte Anne Hospital suggests that anorexia nervosa might not be explained by fear of gaining weight, but by the pleasure of losing it... and that the phenomenon might be genetically influenced. Published in Translational Psychiatry, this study, directed by Prof. Gorwood, head of the Clinic for Mental and Brain Diseases, challenges the notion of fear of weight gain in anorexia patients. | |
 | One hour of driving a day = 2.3kg more weight and 1.5 cm wider waist, study revealsPeople who drive an hour or more a day are 2.3kg heavier and 1.5cm wider around the waist compared to people who spend 15 minutes or less in their cars, research has revealed. |
 | Study uncovers clue to deciphering schizophreniaThe brains of healthy relatives of people with schizophrenia may hold a clue to better understand - and ultimately treat - the devastating illness, finds new research led by a Michigan State University scientist. |
 | New types of blood cancer discovered in childrenThrough a detailed study of leukaemia cells from more than 200 children, a research group at Lund University in Sweden has discovered two new types of childhood leukaemia. Using next-generation sequencing technology (NGS), the researchers were able to study the genome of cancer cells, which is how they discovered the new types of cancer. |
Study throws fat in the fire of diet debateA health study came to the defence of certain dietary fats on Tuesday, adding fuel to a scientific row over low-fat guidelines that have bedevilled dieters for nearly half-a-century. | |
 | Scientists use modelling to show the role of metabolism and signaling in cancer metastasisResearchers have built a model to investigate the metastasis of cancer by examining the metabolism of breast epithelial cells and look at the role of signaling. This research, published in PLOS Computational Biology, may contribute to the development of cell specific anti-cancer interventions. |
 | Neural stem cell transplants promote Parkinson's recovery in non-human primatesA multi-center team of researchers in the U.S. testing the potential of cell therapy for treating Parkinson's disease (PD) has found that grafting human parthenogenetic stem cell-derived neural stem cells (hpNSCs) into non-human primates modeled with PD promoted behavioral recovery, increased dopamine concentrations in the brain, and induced the expression of beneficial genes and pathways when compared to control animals not transplanted with stem cells. |
 | Two in five formerly depressed adults are happy and flourishingA new study reports that approximately two in five adults (39%) who have experienced major depression are able to achieve complete mental health. Researchers consider complete mental health as occurring when people achieve almost daily happiness or life satisfaction, positive social and psychological well-being, and are also free of depression, anxiety, suicidal thoughts and substance abuse for at least one full year. |
Bad behavior may not be a result of bad parenting, but a lack of common languageMost parents will admit that talking with a teenage child is difficult at times. It is even more challenging when parents and children don't speak the same language fluently—a reality for a growing number of immigrant families in the United States. | |
 | Natural killer cells have memoryResearchers at the University of Bonn and the Ludwig-Maximilians-Universität of Munich have decoded a new mechanism of how the immune system can specifically attack pigmented cells of the skin. It was previously believed that so-called natural killer cells did not have an immunological memory for the body's own tissues. However, the scientists have now been able to show that these special immune cells can indeed "remember" pigmented cells when they come into more frequent contact with a specific contact allergen. These results may provide new insights into the development of the skin-depigmenting disease vitiligo but may also offer new options for the treatment of malignant melanoma. These results have now been published in the renowned scientific journal Immunity. |
Mayo Clinic first to implant device to solve fecal incontinenceA clinical team on Mayo Clinic's Florida campus is the first to offer four patients with long-term fecal incontinence a new and potentially long-lasting treatment—a small band of interlinked magnetic titanium beads on a titanium string that successfully mimics the function of the anal sphincter. | |
Maternal weight gain between pregnancies is linked to complications and adverse outcomesWeight gain between pregnancies is linked to pregnancy complications and adverse neonatal outcomes in second born children, according to a study published by Martina Persson and colleagues from the Karolinska Institutet, Stockholm, Sweden, in this week's PLOS Medicine. | |
One-third of children in low- and middle-income countries fail to reach developmental milestonesIn developing countries, one third of children 3 and 4 years old don't reach basic milestones in cognitive and/or socio-emotional growth, according to a new study from the Harvard T.H. Chan School of Public Health, funded by the Government of Canada through Grand Challenges Canada. | |
 | Study charts development of emotional control in teensIn the midst of all the apparent tumult, intense emotion, and occasional reckless behavior characterizing the teenage years, the brain is, in fact, evolving and developing the neural circuits needed to keep emotions in check. Research in the June 8, 2016 issue of The Journal of Neuroscience describes how the ability to control emotions moves from one brain area to another as teens mature into adults, offering an opportunity to understand how disorders related to emotional control emerge. |
 | Preschool academic skills improve only when instruction is good to excellentNew research combining eight large child care studies reveals that preschools prepare children to succeed academically when teachers provide higher quality instruction. |
 | Children who spend extra week in the womb have higher school test scores, risk disabilityResearchers have found that spending a week longer in the womb may give babies a tiny leg up on cognitive ability. The trade-off, however, seems to be a slight increase in the chance of having a physical disability. |
 | Autism with intellectual disability linked to mother's immune dysfunction during pregnancyPregnant women with higher levels of inflammatory cytokines and chemokines, proteins that control communication between cells of the immune system, may be at significantly greater risk of having a child with autism combined with intellectual disability, researchers with the UC Davis MIND Institute have found. |
Mobilizing mitochondria may be key to regenerating damaged neuronsResearchers at the National Institute of Neurological Disorders and Stroke have discovered that boosting the transport of mitochondria along neuronal axons enhances the ability of mouse nerve cells to repair themselves after injury. The study, "Facilitation of axon regeneration by enhancing mitochondrial transport and rescuing energy deficits," which has been published in The Journal of Cell Biology, suggests potential new strategies to stimulate the regrowth of human neurons damaged by injury or disease. | |
 | Quality challenges persist in antipsychotic medication for foster care and other medicaid-covered childrenSignificant quality challenges persist in antipsychotic medication use for children in foster care and other Medicaid-insured children, according to a new Rutgers University-New Brunswick study published in Health Affairs. Overall prescribing rates for children in foster care and other Medicaid-insured children have leveled off since a period of rapid growth in the early and mid-2000s. However, guideline-recommended practices such as use of nonpharmacological mental health services as first-line treatment, and monitoring of blood sugar and cholesterol for metabolic side effects of the medication, are frequently not followed, the research found. |
 | Predicting advanced prostate cancer outcomes with NaF-PET/CTA recent pilot study reported in the June issue of The Journal of Nuclear Medicine found that sodium fluoride (Na-F-18) positron emission tomography/computed tomography (NaF-PET/CT) accurately detects bone metastases in patients with advanced prostate cancer, and follow-up scans over time correlate clearly with clinical outcomes and patient survival. |
 | Stress exposure during pregnancy observed in mothers of children with autismStress during pregnancy has been linked to several conditions, including some instances of autism spectrum disorder. Now, researchers at the University of Missouri School of Medicine have observed a variant of a stress-sensitive gene and exposure to stress during pregnancy among two groups of mothers of children with autism. The researchers believe the finding could be a step toward helping identify women who have greater risks for having children with autism when exposed to stressors during a specific time window during pregnancy. |
 | FDA: People are overdosing on anti-diarrhea drugsFederal health officials are investigating sometimes-deadly overdoses with common anti-diarrhea drugs, a bizarre manifestation of the nation's drug abuse problem. |
Baby born to brain-dead mother in PortugalA healthy baby was born in Portugal on Tuesday to a mother who had been brain-dead for nearly four months. | |
Ramping up treatment of parasitic worm disease cost-effective, researchers findMillions of people in the developing world could be spared from lifelong disability—or possible death—from parasitic worm diseases under a vastly expanded treatment program that is cost-effective, according to a new analysis led by Stanford University School of Medicine researchers. | |
 | Thailand, Belarus, Armenia eliminate mother-child HIV spreadThailand has become the first country in Asia to eliminate mother-to-child transmission of HIV and syphilis, the World Health Organization announced Tuesday. |
 | Do big bottles kickstart infant weight issues?(HealthDay)—Feeding babies formula from a big bottle might put them at higher risk for greater-than-normal weight gain and weight-for-length size, a new study suggests. |
 | U.S. black women get less care to prevent breast cancer return(HealthDay)—Black breast cancer survivors in the United States are less likely than white or Hispanic women to get follow-up genetic screening and surgeries that can help prevent a return of cancer, new research finds. |
 | Pregnant or planning to be? How to protect yourself from Zika virus(HealthDay)—As the threat of the Zika virus grows in the United States, pregnant women and those trying to conceive need to take precautions, a fetal medicine doctor says. |
 | Coming soon: A wearable artificial kidney?Someday, dialysis patients might free themselves of clunky machines, moving about with a "wearable artificial kidney" instead. |
 | Good agreement for doctor, patient criteria for fibromyalgia(HealthDay)—There is good agreement in physician-based (MD) and patient-based (PT) criteria for fibromyalgia diagnosis, according to a study published in the May issue of Arthritis Care & Research. |
 | Review links tonsillectomy to risk of Crohn's disease(HealthDay)—Tonsillectomy is associated with increased risk of developing Crohn's disease (CD), but not ulcerative colitis (UC), according to a review and meta-analysis published in the June issue of the Journal of Gastroenterology and Hepatology. |
 | Intraprocedural CCTA feasible for identifying guidewires(HealthDay)—Coronary computed tomographic angiography (CCTA) is feasible for identifying the location of guidewires during chronic total occlusion (CTO) intervention, according to a study published in the June 15 issue of The American Journal of Cardiology. |
 | Exercise cuts cardiac events in non-metastatic breast cancer(HealthDay)—For patients with non-metastatic breast cancer, exercise is associated with reductions in the incidence of cardiovascular events, according to a study published online May 23 in the Journal of Clinical Oncology. |
 | Opinions vary on management of subclinical hypothyroidism(HealthDay)—Physicians' opinions on management of subclinical hypothyroidism vary, according to a Beyond the Guidelines article published online June 7 in the Annals of Internal Medicine. |
Hong Kong culls thousands of birds over avian flu scareHong Kong culled 4,500 birds on Tuesday after the deadly H7N9 bird flu virus was discovered in a chicken at a local market. | |
 | Depression is associated with vitamin D deficiency among urban Malaysian womenResearchers from the Julius Centre University of Malaya, Department of Social & Preventive Medicine, Faculty of Medicine, University of Malaya, Malaysia found that more than 70% of the urban Malaysian women surveyed were vitamin D deficient ( |
 | A holistic approach to improve breast cancer careA young UWA researcher hopes that one day a simple blood test could screen a breast cancer patient's DNA for cancer related genetic information within each tumour which would alleviate the need for other invasive procedures such as mammography or CT scans. |
Iron could reduce hospitalisation and help ease symptoms for people with failing heartsIron supplement injections could ease the disabling symptoms of heart failure, if a clinical study – known as IRONMAN – proves successful. The trial was officially launched at the British Cardiovascular Society Conference in Manchester. | |
Camera-based monitoring technology measures absolute arterial blood oxygenation (SpO2) levels without contactRoyal Philips today announced the results of the first published study to demonstrate that absolute oxygen saturation of arterial blood (SpO2), a vital sign that is commonly monitored in hospitalized and other patients, can be accurately measured across multiple patients using contactless technology. The study, published in the June issue of the journal Anesthesia & Analgesia, used Philips proprietary camera-based monitoring technology to measure the light reflected off the foreheads of 41 healthy adults to calculate SpO2. Through the results of this study, Philips, a global leader in patient care and monitoring solutions, is the first to demonstrate that contactless SpO2 can be calibrated across patients, just like conventional contact probes, allowing accurate measurements without individual adjustments. | |
Cutting edge technology set to benefit pacemaker patientsA hi-tech improvement to the surgical implantation of pacemakers into patients with heart failure is being pioneered by specialists at Guy's and St Thomas', using software developed by clinicians and engineers at King's College London. | |
Individual support services help people with serious mental illness find employmentApproximately 5% of working-age adults in the United States are impaired by a serious mental illness such as psychotic and severe mood disorders. While about two-thirds of clients with mental illness in community mental health agencies want to work, only about 15% are employed. | |
Stem cells from umbilical cord blood may help treat eczemaA new study suggests that treatment with stem cells from umbilical cord blood might be an effective therapy for patients with moderate-to-severe eczema, or atopic dermatitis. | |
Nordic countries: Highest in gender equality and intimate partner violence against womenThe Nordic countries are the most gender equal nations in the world, but at the same time, they also have a disproportionately high rate of intimate partner violence (IPV) against women. This is perplexing because logically violence against women would be expected to drop as women gained equal status in a society. A new study published in Social Science & Medicine explores this contradictory situation, which has been labeled the "Nordic paradox." Researchers believe that gaining understanding of its underlying causes may offer important tools to help curb the worldwide public health epidemic of violence against women. | |
Ebola map may help prepare for future outbreaksTo be prepared for new Ebola virus disease cases, it is fundamental to start by identifying the range of the virus and the regions that are more favorable for its propagation. A team from the Center of International Forestry Research, Manchester Metropolitan University, and the Universidad de Málaga has led an unprecedented initiative to produce a new and more complete map of the Ebola virus in Africa. Using spatial distribution models, the investigators have applied analytical techniques that indicate where the virus is likely to be found in more favorable conditions. These models take into account a number of non-human mammalian species as well as environmental variables for predicting the presence of the virus. | |
Survival correlation for low versus high enrolling institutions for patients with LA-NSCLCLung cancer is the leading cause of cancer-related death in the United States and is estimated to have contributed to 221,200 new cases and 158,040 deaths in 2015 alone. A secondary analysis of NRG Oncology's clinical trial RTOG 0617, published in the Journal of the National Cancer Institute, was initiated in an effort to evaluate the effect of institution accrual volume on clinical outcomes among patients receiving chemoradiation for locally advanced non-small cell lung cancer (LA-NSCLC). The study showed that patients treated at institutions with higher trial accrual volume on a phase III trial had statistically significant longer overall survival compared with patients treated at low-volume centers. | |
Study examines unsafe behaviors in older adults who likely have dementiaOlder adults who likely have dementia but have not been given the diagnosis are more likely to engage in potentially unsafe activities, new research suggests. | |
Study questions cancer link with bone growth factor for spinal surgeryAdding to previous evidence, a study based on a statewide cancer database shows no increase in cancer risk in patients undergoing spinal fusion surgery with the bone-promoting growth factor recombinant human bone morphogenetic protein (rhBMP). The study appears in Spine. | |
Senate GOP drops push to 'defund Obamacare'Republicans controlling the Senate are abandoning an effort to use their power over the federal purse strings to block implementation of the Affordable Care Act. | |
New test allows for one-step diagnosis of HCV infectionThe current standard in diagnosing Hepatitis C virus (HCV) infection requires two sequential steps that make it suboptimal, costly, inconvenient, time consuming, and globally not widely available or affordable. Now researchers have developed a novel enzyme immunoassay that accomplishes screening and diagnosis in one simple and affordable step. | |
Anti-epileptic drug linked to birth defects when taken with other drugsIn an analysis of pregnancies in Australia from 1999 to 2014 in which women were taking anti-epileptic drugs, fetal malformation rates fell over time in pregnancies where only one drug was taken, but rates increased in pregnancies where multiple drugs were taken. | |
 | Automated OCL insulin system shown to improve glucose control for youngsters at diabetes campUsing an automated insulin feedback controller as part of an overnight closed-loop (OCL) control system improved glucose control (increased time within target glucose range) and reduced episodes of nocturnal hypoglycemia in children and adolescents. The design and key findings of this study, which are particularly promising because the youngsters were living in the challenging environment of a diabetes camp, are reported in Diabetes Technology & Therapeutics (DTT), a peer-reviewed journal from Mary Ann Liebert, Inc., publishers. The article is available free on the DTT website until July 7, 2016. |
Medical aid group urges better HIV treatment in West AfricaGovernments need to improve access to HIV treatment in West and Central Africa, where critical medicines reach less than one-third of those in need, Doctors Without Borders said Tuesday. | |
Fat tissue shows a robust circadian rhythm in a dishIn humans, glucose tolerance varies with time of day, but the mechanism responsible for the variation in insulin sensitivity throughout the day is unclear. In a recent study in The Journal of the Federation of American Societies for Experimental Biology, researchers from Brigham and Women's Hospital and the University of Murcia investigated whether human adipose (fat) tissue possesses its own circadian rhythm in insulin sensitivity that could contribute to this phenomenon. | |
Biology news
 | Fish can recognize human faces, new study showsA species of tropical fish has been shown to be able to distinguish between human faces. It is the first time fish have demonstrated this ability. |
 | Engineered E. coli vesicles act as vaccine deliverersMention E. coli and what pops into most people's heads are bacteria, tainted food, a rush to the hospital – basically, fear. |
 | Scientists identify protein which boosts rice yield by fifty percentIn collaboration with researchers at Nanjing Agricultural University, Dr Tony Miller from the John Innes Centre has developed rice crops with an improved ability to manage their own pH levels, enabling them to take up significantly more nitrogen, iron and phosphorous from soil and increase yield by up to 54 percent. |
 | Modelling auditory systems of bats for information processing applicationsScientists have developed a neural network model of a bat's auditory system to understand how bats rapidly discriminate between signals from edible insects and surrounding background noise. The report by researchers at UEC, Tokyo is published Neural Processing Letters. |
 | Cellular receptors for human cytomegalovirus discoveredA publication in the scientific journal Nature Microbiology identifies PDGFRα as the receptor for the trimeric gHgLgO complex of Human cytomegalovirus (HCMV). TThe study led by the Institute for Research in Biomedicine (IRB) affiliated to the Università della Svizzera italiana (USI) was done in collaboration with scientists from Humabs BioMed SA in Switzerland, the IRCCS Policlinico San Matteo, the Istituto Nazionale Genetica Molecolare in Milan, Italy and the Vaccine Research Center (VRC) of the American National Institutes of Health (NIH). |
As temperatures rise, flowers emit reduced scentThe diverse and delicious fragrances of flowers brighten our days and inspire poetry. The more practical reason that flowers produce scent is to attract pollinating insects to the flowers' reproductive organs, thereby ensuring the continued existence of plant species. To do this, flowers assemble a mixture of dozens, and sometimes hundreds, of volatile substances from several biochemical groups. | |
 | Prescribed burning may benefit rattlesnakesA forest at first appears devastated after a fire, devoid of color. Ash and smoky plant remains cover the forest floor. In a few short weeks, however, shrubs and forbs will poke through the ash, taking advantage of the nitrogen that was released during the fire. Turkeys will feed on the remains of dead insects, and small mammals will emerge from their burrows to feed on seeds of oaks and hickories, whose thick bark protected them from the heat of the fire. |
 | Solved mystery of the deep-sea mushroom just raises new questionsIt's not often scientists suggest they've found an entirely new group of animals, something so different that they can't be considered as belonging to one of the main groups, such as shellfish, insects, worms, jellyfish, sponges, animals with backbones (like us) and so on. |
 | Top brands failing on cotton sustainabilityThe majority of international companies using most cotton globally are failing to deliver on cotton sustainability according to new independent research published today by Pesticide Action Network (PAN) UK, Solidaridad and WWF. |
 | Researchers develop method to produce sweeter, well-growing tomatoesPrevious research has shown that the sugar sucrose plays a role in controlling key fruit genes involved in sugar metabolism. Efforts to control these genes succeeded in increasing the sugar content in fruit but also resulted in stunted growth. |
 | Bacteria hairs make excellent electrical wiresAlthough proteins are usually electrically insulating, hair-like nanoscale filaments (called pili) on the surface of Geobacter bacteria exhibit metallic-like conductivity. To understand why pili are conductive, scientists from the University of Massachusetts at Amherst, Holy Cross, and Brookhaven National Laboratory recently used X-ray diffraction to analyze the structure of the filaments. They found that the electronic arrangement and the small molecular separation distances (~0.3 nanometers) give the pili an electrical conductivity comparable to that of copper. |
| Study links tobacco microbials, carcinogensUniversity of Kentucky researchers have found a link between changes in microbial communities on tobacco leaves and the development of carcinogens during the curing process. |
 | What makes a small worm a popular modelResearchers from the Friedrich Schiller University Jena and Kiel University have compiled all metabolic pathways of the model organism Caenorhabditis elegans described so far and have presented a comprehensive metabolic model in the current edition of the journal Cell Systems. The model, called "ElegCyc", covers about 2,000 metabolic processes and is available to research groups all over the world. |
 | Deer make collision-free escapes thanks to inbuilt 'compasses'Why do deer in a group, when startled, suddenly bolt away together and never collide with each other? It's because these deer have an inner compass that allows them to follow a certain direction in order to make their escape. Their getaway is almost always along a north-south axis, thanks to their ability to sense the magnetic field, says Petr Obleser of the Czech University of Life Sciences in the Czech Republic. He and Hynek Burda of the University Duisburg-Essen, Germany, are lead authors of a study in Springer's journal Behavioral Ecology and Sociobiology. |
 | So 1 dog year equals 7 people years? Not so fast...Everyone says it: One year for a dog equals seven years for a human. But like a lot of things everyone says, it's wrong. |
 | Bats are transmitters of dangerous human infectionsTomsk State University zoologist Maria Orlova participated in an international research project dedicated to parasites of bats from Mexico and the Antilles. The study proved that both parasites and bats can act as the transmitters of dangerous human infections. |
Research program studies industrial hempNorth Dakota farmers are growing industrial hemp for the first time in more than 70 years, and the New Crops research program in the NDSU Department of Plant Sciences is conducting research to assist them. | |
 | Farm-to-food study aims to understand the effect of manure management practices on antibiotic resistance and residuesResearchers from four U.S. universities are teaming up with dairy farms across the Northeast and Mid-Atlantic to study the effect of three different manure management techniques on preventing the occurrence and spread of antimicrobial-resistant bacteria, genes tied to resistance, and antibiotic residues—traces of antibiotics and the compounds they break down into. |
Recent research uncovers surprises about antibiotic resistanceIt's thought that antibiotic resistance is associated with a fitness cost, meaning that bacteria that develop antibiotic resistance must sacrifice something in order to do so. Because of this, proper use of antibiotics should result in susceptible strains eventually replacing resistant ones. | |
New research on snakes may provide insights on evolutionPythons and boas are distantly related, but new research indicates that they have evolved convergent physical characteristics when living in similar habitats—meaning that they evolved similar solutions to similar problems. | |
 | New baby warthogs get ready for Oakland Zoo debutThe Oakland Zoo has welcomed two litters of baby warthogs and will soon put the seven piglets on display. |
This email is a free service of Science X Network
You received this email because you subscribed to our list.
If you no longer want to receive this email use the link below to unsubscribe.
https://sciencex.com/profile/nwletter/
You are subscribed as jmabs1@gmail.com
No comments:
Post a Comment